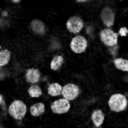

Robust and accurate nuclei centroid detection is important for the understanding of biological structures in fluorescence microscopy images. Existing automated nuclei localization methods face three main challenges: (1) Most of object detection methods work only on 2D images and are difficult to extend to 3D volumes; (2) Segmentation-based models can be used on 3D volumes but it is computational expensive for large microscopy volumes and they have difficulty distinguishing different instances of objects; (3) Hand annotated ground truth is limited for 3D microscopy volumes. To address these issues, we present a scalable approach for nuclei centroid detection of 3D microscopy volumes. We describe the RCNN-SliceNet to detect 2D nuclei centroids for each slice of the volume from different directions and 3D agglomerative hierarchical clustering (AHC) is used to estimate the 3D centroids of nuclei in a volume. The model was trained with the synthetic microscopy data generated using Spatially Constrained Cycle-Consistent Adversarial Networks (SpCycleGAN) and tested on different types of real 3D microscopy data. Extensive experimental results demonstrate that our proposed method can accurately count and detect the nuclei centroids in a 3D microscopy volume.
翻译:现有自动核心本地化方法面临三大挑战:(1) 多数物体探测方法只对2D图像起作用,难以推广到3D卷;(2) 3D卷可以使用基于分解的模型,但对于大型显微镜卷来说,这种模型计算成本很高,难以区分不同对象;(3) 3D显微镜卷的附加说明的地面真象有限;为解决这些问题,我们提出了一个可测量的3D显微镜卷探测核体积的方法。我们描述RCNNN-CliceNet用于检测2D微晶体积的每一片的2D核圆球体,从不同方向探测,3D高集层集集成(AHC)用于估算3D核体体体积,它们难以区分不同的对象;为3D显微镜卷的3D核体体积。该模型是用利用空间控制循环中心显微显微镜数据生成的。我们描述RCN-S-CliceNet用于探测2D微晶体卷体积的2D核核圆球体体体,并测试了我们提出的3crobyGAN的模型模型模型,并准确地测量了我们提出的3croup 3climcal 的模型。